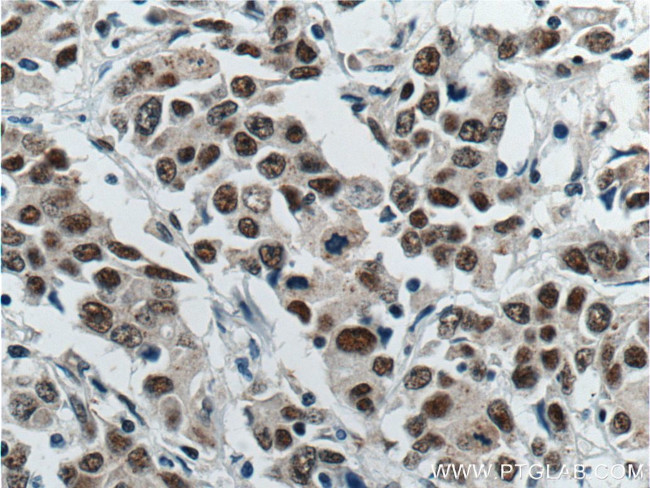
ATF7IP Antibody in Immunohistochemistry (Paraffin) (IHC (P))

Search
Proteintech
ATF7IP Polyclonal Antibody
{{$productOrderCtrl.translations['antibody.pdp.commerceCard.promotion.promotions']}}
{{$productOrderCtrl.translations['antibody.pdp.commerceCard.promotion.viewpromo']}}
{{$productOrderCtrl.translations['antibody.pdp.commerceCard.promotion.promocode']}}: {{promo.promoCode}} {{promo.promoTitle}} {{promo.promoDescription}}. {{$productOrderCtrl.translations['antibody.pdp.commerceCard.promotion.learnmore']}}
产品信息
14699-1-AP
种属反应
宿主/亚型
分类
类型
抗原
偶联物
形式
浓度
规格
纯化类型
保存液
内含物
保存条件
运输条件
产品详细信息
Immunogen sequence: NTATVVATT QVPSGNPQPT ISLQPLPVIL HVPVAVSSQP QLLQSHPGTL VTNQPSGNVE FISVQSPPTV SGLTKNPVSL PSLPNPTKPN NVPSVPSPSI QRNPTASAAP LGTTLAVQAV PTAHSIVQAT RTSLPTVGPS GLYSPSTNRG PIQMKIPISA FSTSSAAEQN SNTTPRIENQ TNKTIDASVS KKAADSTSQC GKATGSDSSG VIDLTMDDEE SGASQDPKKL NHTPVSTMSS SQPVSRPLQP IQPAPPLQPS GVPTSGPSQT TIHLLPTAPT TVNVTHRPVT QVTTRLPVPR APANHQVVYT TLPAPPAQAP LRGTVMQAPA VRQVNPQNSK RFFLYMAPRY M (756-1106 aa encoded by BC063855)
靶标信息
ATF7IP is a multifunctional nuclear protein that associates with heterochromatin. It can act as a transcriptional coactivator or corepressor depending upon its binding partners.
仅用于科研。不用于诊断过程。未经明确授权不得转售。
生物信息学
蛋白别名: Activating transcription factor 7-interacting protein 1; ATF-interacting protein; ATF-IP; ATF7-interacting protein; ATFa-associated Modulator; FLJ10688; hAM; mAM; MBD1-containing chromatin-associated factor 1; P621; transcriptional mediator; unnamed protein product
基因别名: 2610204M12Rik; AM; ATF-IP; ATF7IP; ATF7IP1; MCAF; MCAF1; p621
UniProt ID: (Human) Q6VMQ6, (Mouse) Q7TT18
Entrez Gene ID: (Human) 55729, (Mouse) 54343, (Rat) 312800